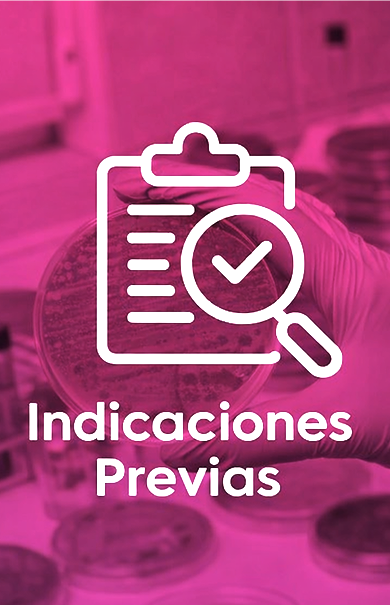
null

Contarás con especialistas de amplia experiencia, así como con equipos y tecnología de última generación, dando respuesta a todas las inquietudes generadas en nuestros pacientes de forma oportuna.
Más de 500 exámenes de laboratorio analizados con la confianza y calidad que nos caracteriza.